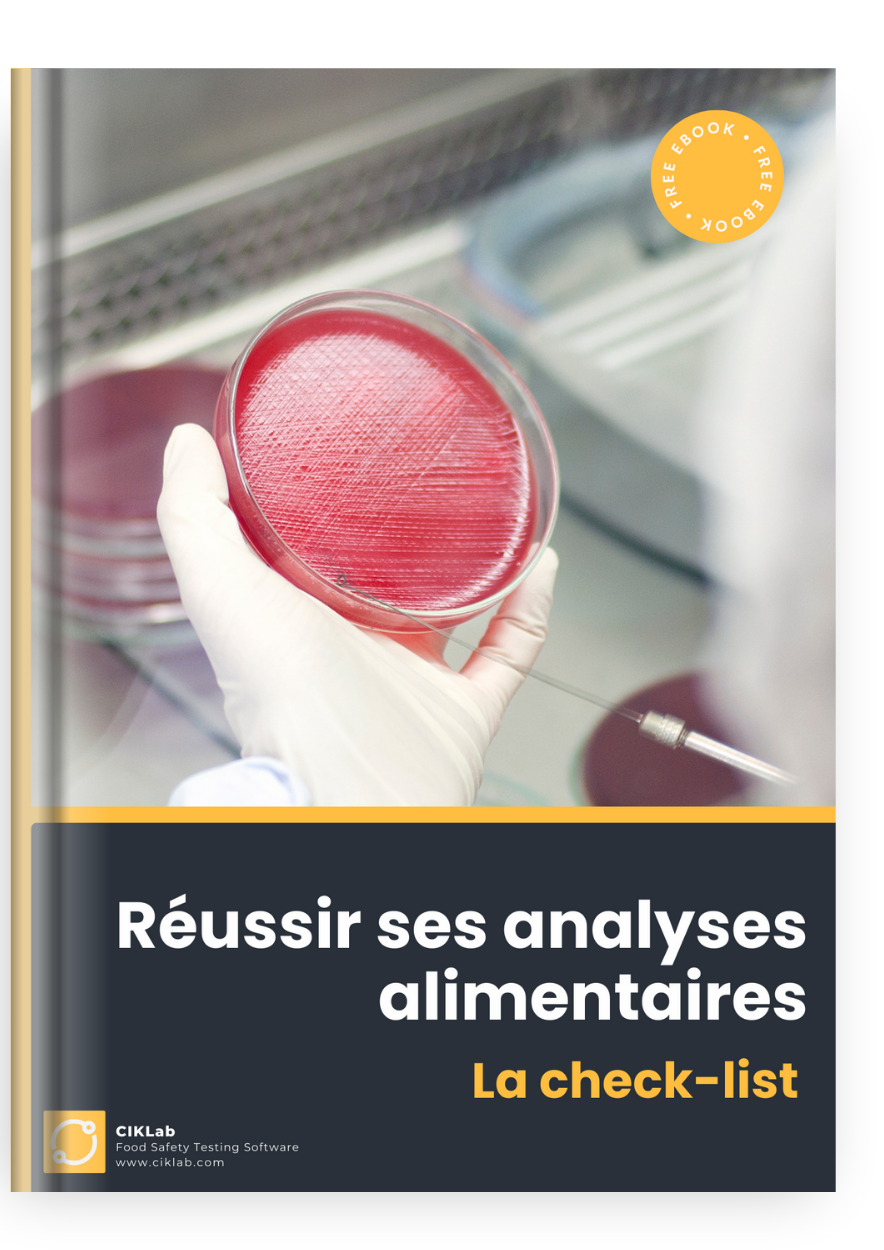
Réussir ses analyses alimentaires 4

CHECK-LIST
✅ 30 étapes indispensables pour réussir vos analyses alimentaires !
Avec cette checklist, gagnez du temps en ayant le détail de toutes les étapes pour :
👉 mettre en place votre plan de contrôle
👉 sélectionner vos laboratoires sous-traitants
👉 gérer le contrôle qualité des lots
Vous y trouverez également des conseils, des ressources et des outils pour faciliter vos analyses de contrôle qualité !
Les professionnels du contrôle qualité font confiance à CIKLab !




